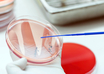

Doctors' Lifestyle, Work and Motivation survey – Part 2
M3 India Newsdesk | May 03, 2017
10 Breakthroughs In Obesity Management
M3 India Newsdesk | May 02, 2017
What's new for pneumonia? Five innovative antibiotics in the pipeline
M3 Global Newsdesk | Apr 29, 2017
10 Exciting Breakthroughs in Cancer Treatment
M3 India Newsdesk | Apr 28, 2017
Patient Data Focused Technologies — Boon for the Healthcare Industry?
M3 India Newsdesk | Apr 26, 2017
Why Is India Still Dealing With TB?
M3 India Newsdesk | Apr 24, 2017
No More On A Pedestal? The New Doctor - Patient Relationship
M3 India Newsdesk | Apr 19, 2017
The Tough Road to Becoming A Doctor In India
M3 India Newsdesk | Apr 14, 2017
Doctor, Is Working the Graveyard Shift Killing You?
M3 India Newsdesk | Apr 12, 2017
Health Policies: Who Are the Real Decision-Makers?
M3 India Newsdesk | Apr 10, 2017
Most read this week